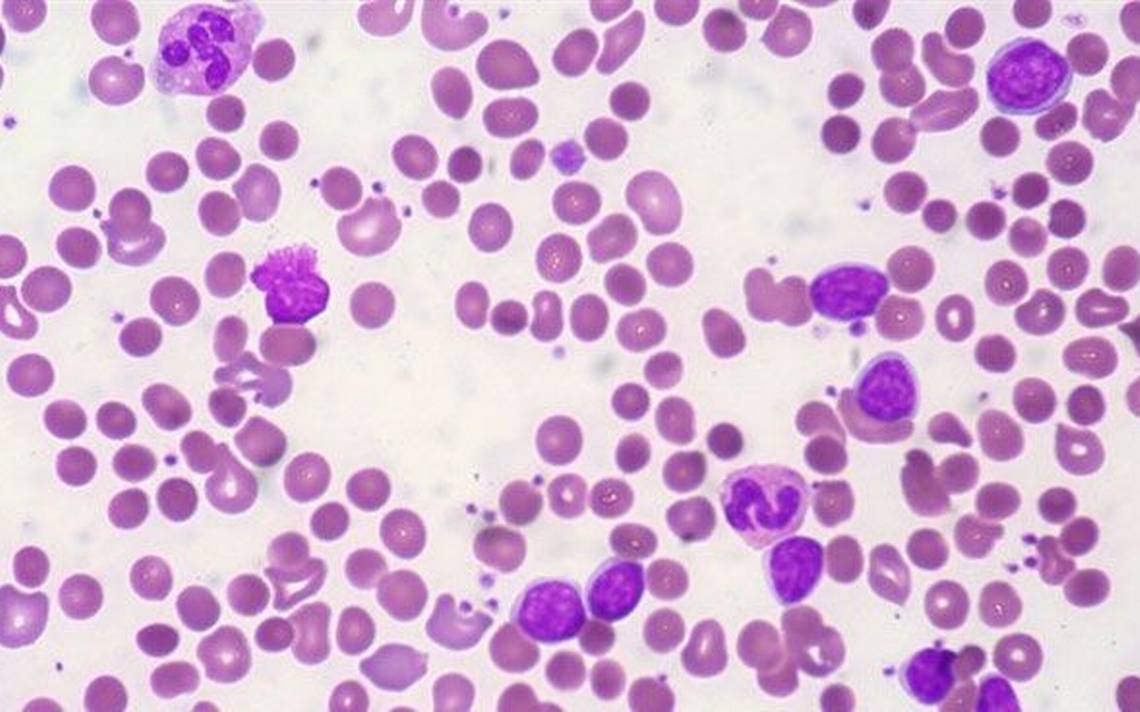

Farmacología

Trasplante de médula ósea con donante haploidéntico vs no relacionado
21 diciembre 2020
Este estudio compara los resultados de una gran cohorte de pacientes con enfermedades malignas, según el tipo de donante de células madre utilizado. El trasplante haploidéntico tuvo una mortalidad sin recaída similar, pero una supervivencia general más baja que el trasplante con donante no emparentado. Medicina (Buenos Aires), diciembre de 2020.
Inhibidores de PARP y complicaciones hematológicas tardías
21 diciembre 2020
Los inhibidores de PARP aumentan el riesgo de síndrome mielodisplásico y leucemia mieloide aguda en comparación con el placebo. Estos eventos adversos retardados y a menudo letales deben estudiarse más a fondo para mejorar la comprensión clínica, particularmente en el entorno de mantenimiento de primera línea. The Lancet Haematology, 18 de diciembre de 2020.

Capecitabina en el cáncer de mama triple negativo temprano
15 diciembre 2020
En las mujeres con cáncer de mama triple negativo en estadio temprano que recibieron el tratamiento adyuvante estándar, el mantenimiento con capecitabina en dosis bajas durante 1 año mejoró la supervivencia libre de enfermedad a 5 años. JAMA, 10 de diciembre de 2020.

Cirugía hepática abierta vs laparoscópica en el cáncer colorrectal metastásico
19 noviembre 2020
En este ensayo clínico aleatorizado de cirugía hepática laparoscópica y abierta, no se encontraron diferencias en los resultados de supervivencia entre los grupos de tratamiento, aunque por el tamaño de la muestra no se pueden excluir diferencias significativas en una u otra dirección. Annals of Internal Medicine, 18 de noviembre de 2020.

Evidencia de ensayos clínicos que respalda la aprobación de nuevas terapias contra el cáncer por parte de la Administración de Alimentos y Medicamentos de EE. UU. Entre 2000 y 2016
13 noviembre 2020
